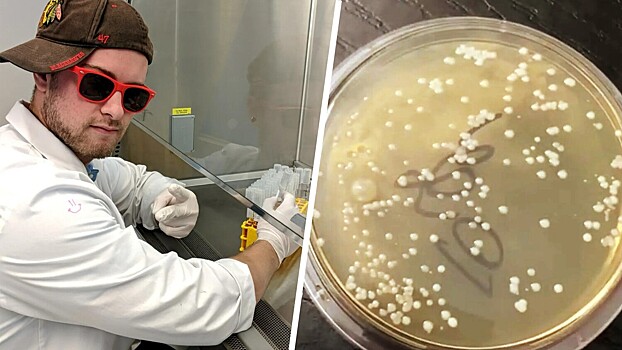
Микробиолог провел эксперимент и показал, почему нельзя есть еду с пола

Daily Mail: ученый в США провел эксперимент и показал, почему нельзя есть еду с пола
Ученый из США рассказал, почему нельзя есть еду с пола, пишет The Sun.
Микробиолог Николас Айхер из Чикаго провел любопытный эксперимент, проверяя известное «правило пяти секунд». Как старший аналитик по контролю качества, он регулярно делится исследованиями чистоты повседневных предметов со своей аудиторией. На этот раз ученый продемонстрировал, как быстро бактерии попадают на пищу с пола.
Для эксперимента Николас помещал кусок пластика на пол на разные промежутки времени: менее секунды, 5, 10, 20, 30 секунд и целую минуту. После этого он инкубировал образцы и изучал рост бактерий. Результаты оказались неожиданными: даже при мгновенном контакте с поверхностью на образце обнаруживались микробы.
«Похоже, даже ноль секунд — это слишком долго», — прокомментировал Айхер.
Любопытно, что количество бактерий на образцах, пролежавших 5 и 60 секунд, оказалось примерно одинаковым. Наибольший рост микроорганизмов наблюдался на образцах, контактировавших с полом 10-30 секунд.
«Пять секунд или минута — в любом случае будет неприятно», — заключил Николас.
Эти данные полностью опровергают популярный миф о безопасности кратковременного контакта пищи с полом. Эксперимент вызвал бурную реакцию зрителей. Многие признались, что больше никогда не станут поднимать и есть упавшую еду.